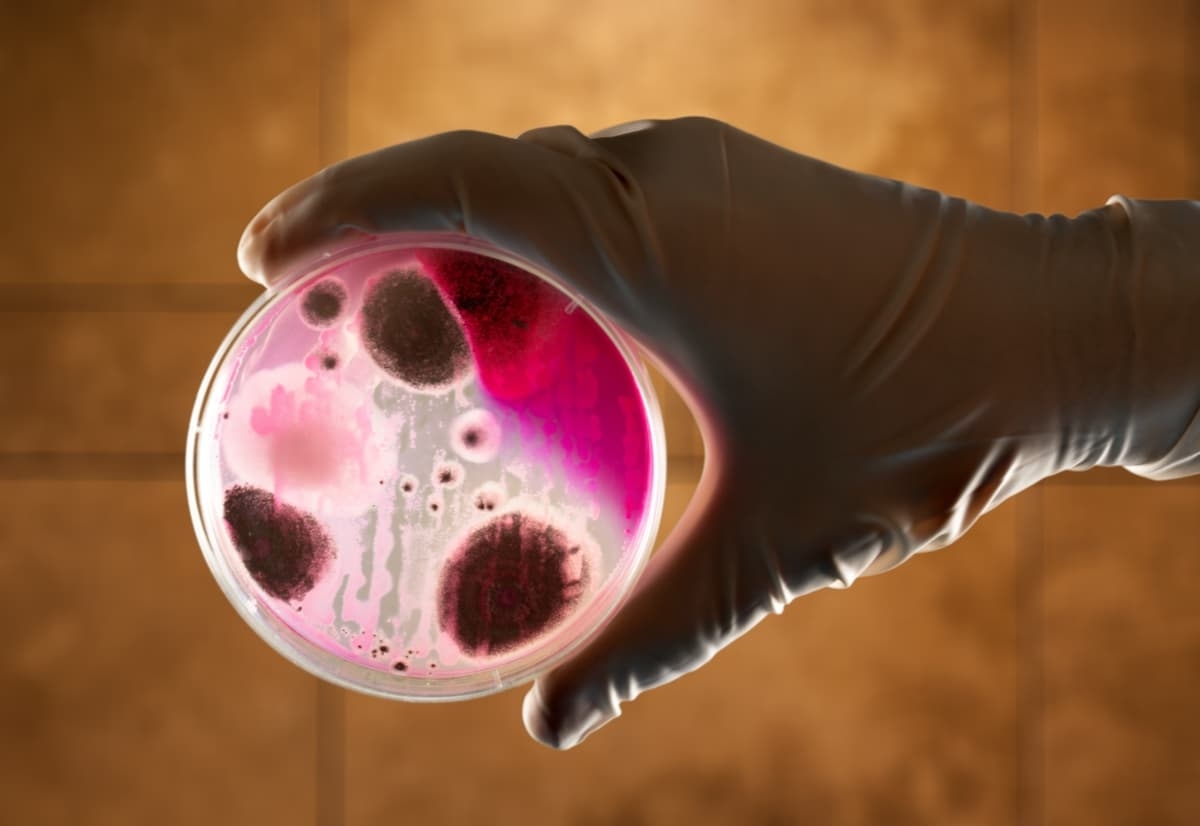
Şarbon Hastalığı Nedir?

Şarbon, Bacillus anthracis adlı bakterinin neden olduğu bir bakteriyel enfeksiyondur. Genellikle hayvanlardan insanlara bulaşır ve deri, akciğerler veya sindirim sistemini etkileyebilir. Deri şarbonu kırmızı lezyonlarla başlar, akciğer şarbonu grip benzeri semptomlara neden olurken, sindirim sistemi şarbonu mide ağrısı ve kusma gibi belirtilere yol açabilir. Erken teşhis ve uygun antibiyotik tedavisi önemlidir, ayrıca aşılama risk altındaki bireylere önerilmektedir.
Şarbon Hastalığı Nedir?
Şarbon, Bacillus anthracis adlı bakterinin neden olduğu bir bakteriyel enfeksiyondur. Bu bakteri genellikle hayvanlarda bulunur ve enfekte hayvanların doku, deri veya vücut sıvıları ile temas sonucu insanlara bulaşabilir. Şarbon, genellikle deri, akciğerler veya sindirim sistemini etkileyebilir.
Şarbonun Belirtileri Nelerdir?
Deri Şarbonu:
- En yaygın türdür.
- Kırmızı renkli bir lezyon veya sivilce ile başlar.
- Zamanla lezyon büyüyerek yara, kabuk bağlamış bir yara veya siyah renkli bir yara haline gelebilir.
Akciğer Şarbonu:
- Solunum yoluyla bulaşır.
- Başlangıçta grip benzeri semptomlar (ateş, öksürük, nefes darlığı) gösterir.
- Daha sonra şiddetli solunum yetmezliği ve şok ortaya çıkabilir.
Sindirim Sistemi Şarbonu:
- Kontamine et ile bulaşabilir.
- Ağız, boğaz ve bağırsaklarda ülserlere neden olabilir.
- Ateş, mide ağrısı, kusma gibi belirtiler görülebilir.
Şarbonun Tedavisi Nedir?
Şarbon tedavisi, erken teşhis ve uygun antibiyotik kullanımı ile mümkündür. Antibiyotikler, genellikle penisilin veya sefalosporin gibi ilaçlar, bakteriyi öldürmeye yöneliktir. Tedavi edilmezse, şarbon ölümcül olabilir, bu nedenle şüpheli durumlarda bir sağlık profesyoneline başvurmak önemlidir.
Ayrıca, şarbona karşı aşılama da özellikle risk altındaki kişilere (örneğin, çiftçiler, hayvanlarla çalışanlar) önerilmektedir. İnsanlar, enfekte hayvanlar veya enfekte hayvan ürünleriyle temas etmekten kaçınmalı ve işle ilgili güvenlik önlemlerini almalıdır.

Yorum Yap
Misafir olarak yorum yapıyorsunuz. Giriş Yap
Yorumunuzun kontrolden geçtikten sonra yayınlanacaktır.